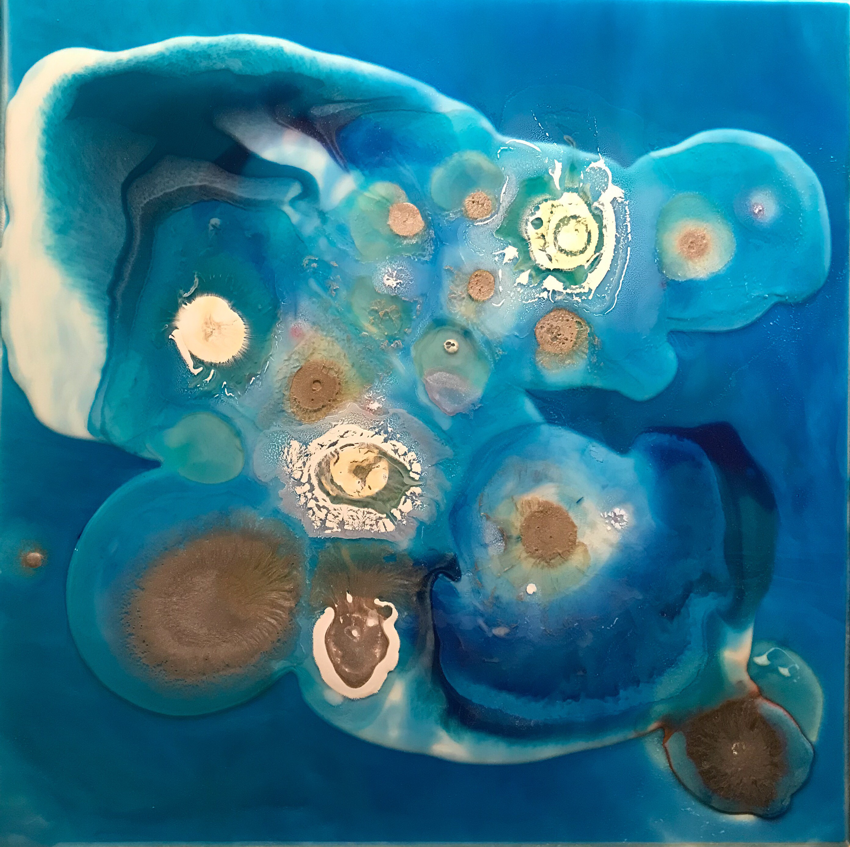

Ewelina Naumnik urodziła się w Białymstoku we wschodniej Polsce w 1975 roku. Dorastając w mieście w czasach rodzącej się demokracji odkrywała nowe możliwości i wyzwania. Wcześnie się usamodzielniła łącząc role rodzica, pracownika, przedsiębiorcy od niedawna także wolontariusza w zarządzanej przez siebie fundacji. W wieku dojrzewania Ewelina była zafascynowana malarstwem i tym, jak świat jest prezentowany oczami innych. Z natury humanistka, zainspirowana zmianami politycznymi ukończyła studia politologiczne. Nabierała coraz większej odwagi w obrazowaniu własnej perspektywy. Początkowo poprzez fotografię, grafikę i malarstwo, pilnie obserwując warsztat doświadczonych artystów i odważnie eksperymentując z nowymi technikami i mediami. Ewelina przemawia poprzez abstrakcję, zafascynowana kolorem, ruchem i formą. Inspirują ją klasycy abstrakcyjnego ekspresjonizmu tj. Helen Fankenthaler, Jackson Pollock, Clyfford Still, Robert Natkin i współcześni przedstawiciele gatunku tj: Gunther Forg, Vinn Wong, Kristina Quinones. Ewelina ma wiele zainteresowań, stale odkrywa i poszukuje nowych przestrzeni kreatywnego myślenia. Tworzy w ciszy, swojego podświadomego działania, instynktownych wyborów i intuicyjnych decyzji. Uwielbia czas narastania idei, wizji kreacji, po którym następuje etap skrupulatnych przygotowań warsztatu, a po nim wspaniały akt tworzenia który trwa nieustannie aż do momentu pełnej satysfakcji. Tak jak w życiu jest multidyscyplinarna i swobodnie wykonuje wiele działań jednocześnie, tak w okresach tworzenia całą uwagę kieruje na proces twórczy aż do zakończenia pracy. Radość życia, entuzjazm i pasję przelewa na płótno tworząc nawet kilka prac jednocześnie. Wyróżniona w 2018 roku Platynową nagrodą ArtMajeur Gallery, przyjęła zaproszenie do udziału w wystawie pt.: "Revelazioni” w Merlino Gallery we Florencji w maju 2018 roku co owocuje kolejną wystawą pt.: "Chromatic vibrations” w 809 Art Gallery w Madiolanie.
Ewelina mieszka i pracuje w niewielkiej wsi w okolicach Białegostoku, w sąsiedztwie czterech parków krajobrazowych. Obcuje z naturą, żyje w otoczeniu wielu przyjaciół i kochającej rodziny, dużo podróżuje i często zmienia otoczenie.
technika mieszana na płycie HDF, 50 x 50 cm
sygnowany na odwrociu: ‘Ewelina Naumnik 2018’
nalepka autorska na odwrociu
Ewelina Naumnik urodziła się w Białymstoku we wschodniej Polsce w 1975 roku. Dorastając w mieście w czasach rodzącej się demokracji odkrywała nowe możliwości i wyzwania. Wcześnie się usamodzielniła łącząc role rodzica, pracownika, przedsiębiorcy od niedawna także wolontariusza w zarządzanej przez siebie fundacji. W wieku dojrzewania Ewelina była zafascynowana malarstwem i tym, jak świat jest prezentowany oczami innych. Z natury humanistka, zainspirowana zmianami politycznymi ukończyła studia politologiczne. Nabierała coraz większej odwagi w obrazowaniu własnej perspektywy. Początkowo poprzez fotografię, grafikę i malarstwo, pilnie obserwując warsztat doświadczonych artystów i odważnie eksperymentując z nowymi technikami i mediami. Ewelina przemawia poprzez abstrakcję, zafascynowana kolorem, ruchem i formą. Inspirują ją klasycy abstrakcyjnego ekspresjonizmu tj. Helen Fankenthaler, Jackson Pollock, Clyfford Still, Robert Natkin i współcześni przedstawiciele gatunku tj: Gunther Forg, Vinn Wong, Kristina Quinones. Ewelina ma wiele zainteresowań, stale odkrywa i poszukuje nowych przestrzeni kreatywnego myślenia. Tworzy w ciszy, swojego podświadomego działania, instynktownych wyborów i intuicyjnych decyzji. Uwielbia czas narastania idei, wizji kreacji, po którym następuje etap skrupulatnych przygotowań warsztatu, a po nim wspaniały akt tworzenia który trwa nieustannie aż do momentu pełnej satysfakcji. Tak jak w życiu jest multidyscyplinarna i swobodnie wykonuje wiele działań jednocześnie, tak w okresach tworzenia całą uwagę kieruje na proces twórczy aż do zakończenia pracy. Radość życia, entuzjazm i pasję przelewa na płótno tworząc nawet kilka prac jednocześnie. Wyróżniona w 2018 roku Platynową nagrodą ArtMajeur Gallery, przyjęła zaproszenie do udziału w wystawie pt.: "Revelazioni” w Merlino Gallery we Florencji w maju 2018 roku co owocuje kolejną wystawą pt.: "Chromatic vibrations” w 809 Art Gallery w Madiolanie.
Ewelina mieszka i pracuje w niewielkiej wsi w okolicach Białegostoku, w sąsiedztwie czterech parków krajobrazowych. Obcuje z naturą, żyje w otoczeniu wielu przyjaciół i kochającej rodziny, dużo podróżuje i często zmienia otoczenie.